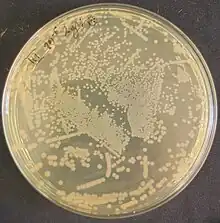

Pseudomonas gessardii
| Pseudomonas gessardii | |
|---|---|
![]() | |
| Pseudomonas gessardii on LB agar | |
| Scientific classification | |
| Domain: | Bacteria |
| Phylum: | Pseudomonadota |
| Class: | Gammaproteobacteria |
| Order: | Pseudomonadales |
| Family: | Pseudomonadaceae |
| Genus: | Pseudomonas |
| Species: | P. gessardii |
| Binomial name | |
| Pseudomonas gessardii Verhille, et al., 1999 | |
| Type strain | |
| CIP 105469 CFML 95-251 | |
Pseudomonas gessardii is a fluorescent, Gram-negative, rod-shaped bacterium isolated from natural mineral waters in France.[1] Based on 16S rRNA analysis, P. gessardii has been placed in the P. fluorescens group.[2]
Habitat
While as mentioned previously this bacterium was first isolated from natural mineral water, it is also found in other environments such as sewage[3] or soil.[4] These bacteria have a wide range of thermal tolerance as they can grow at temperatures ranging from 4 to 35°C with an optimum at 30°C.[1]
Industrial applications
Pseudomonas gessardii bacteria are currently used in many industrial processes. Examples of these applications include bioremediation of contaminated industrial sites through degradation of naphthalene and biological reduction of chromium for its removal from the environment,[3] production of lipase active in low pH conditions used in the food, leather and medical industries[5]</ref> and production of xylitol from organic agro-industrial waste.[6]
This bacterium also has the potential to function as a plant growth promoter. It has been proven that inoculation of soil contaminated with lead (Pb) with these bacteria causes its immobilization, increased plant growth, increased chlorophyll content and yields.[7] Another beneficial feature of these bacteria is their ability to protect the plants with which they form symbiosis against pathogenic microorganisms. This is due to its ability to produce compounds such as chitinases with fungicidal activity or lipases and proteases with antibacterial activity. Additional benefits of treating plants with these bacteria result from the fact that they produce siderophores increasing the content of iron available to plants.[4] Another feature of this species is its ability to form plant growth-promoting bacterial consortia with other beneficial bacteria, in which these microorganisms interact with each other in a way that maximizes their beneficial effects on the plants. These consortiums allow for more effective fixation of atmospheric nitrogen and increasein the bioavailability of elements such as phosphorus and potassium in the soil compared to single-species populations.[8]
References
- 1 2 Verhille S, Baïda N, Dabboussi F, Hamze M, Izard D, Leclerc H (October 1999). "Pseudomonas gessardii sp. nov. and Pseudomonas migulae sp. nov., two new species isolated from natural mineral waters". International Journal of Systematic Bacteriology. 49 Pt 4 (4): 1559–1572. doi:10.1099/00207713-49-4-1559. PMID 10555337.
- ↑ Anzai Y, Kim H, Park JY, Wakabayashi H, Oyaizu H (July 2000). "Phylogenetic affiliation of the pseudomonads based on 16S rRNA sequence". International Journal of Systematic and Evolutionary Microbiology. 50 Pt 4 (4): 1563–1589. doi:10.1099/00207713-50-4-1563. PMID 10939664.
- 1 2 Huang H, Wu K, Khan A, Jiang Y, Ling Z, Liu P, et al. (May 2016). "A novel Pseudomonas gessardii strain LZ-E simultaneously degrades naphthalene and reduces hexavalent chromium". Bioresource Technology. 207: 370–378. Bibcode:2016BiTec.207..370H. doi:10.1016/j.biortech.2016.02.015. PMID 26901089.
- 1 2 Shurigin V, Alimov J, Davranov K, Gulyamova T, Egamberdieva D (2022). "The diversity of bacterial endophytes from Iris pseudacorus L. and their plant beneficial traits". Current Research in Microbial Sciences. 3: 100133. doi:10.1016/j.crmicr.2022.100133. PMC 9325737. PMID 35909614.
- ↑ Ramani K, Chockalingam E, Sekaran G (May 2010). "Production of a novel extracellular acidic lipase from Pseudomonas gessardii using slaughterhouse waste as a substrate". Journal of Industrial Microbiology & Biotechnology. 37 (5): 531–5. doi:10.1007/s10295-010-0700-2. PMID 20204455.
- ↑ Ahuja V, Bhatt AK, Mehta S, Sharma V, Rathour RK (June 2022). "Xylitol production by Pseudomonas gessardii VXlt-16 from sugarcane bagasse hydrolysate and cost analysis". Bioprocess and Biosystems Engineering. 45 (6): 1019–1031. doi:10.1007/s00449-022-02721-z. PMID 35355104.
- ↑ Raza Altaf A, Teng H, Saleem M, Raza Ahmad H, Adil M, Shahzad K (2021-04-03). "Associative interplay of Pseudomonas gessardii BLP141 and pressmud ameliorated growth, physiology, yield, and Pb-toxicity in sunflower". Bioremediation Journal. 25 (2): 178–188. Bibcode:2021BiorJ..25..178R. doi:10.1080/10889868.2020.1853028. ISSN 1088-9868.
- ↑ Kaur T, Devi R, Kumar S, Sheikh I, Kour D, Yadav AN (April 2022). "Microbial consortium with nitrogen fixing and mineral solubilizing attributes for growth of barley (Hordeum vulgare L.)". Heliyon. 8 (4): e09326. Bibcode:2022Heliy...809326K. doi:10.1016/j.heliyon.2022.e09326. PMC 9062246. PMID 35520606.